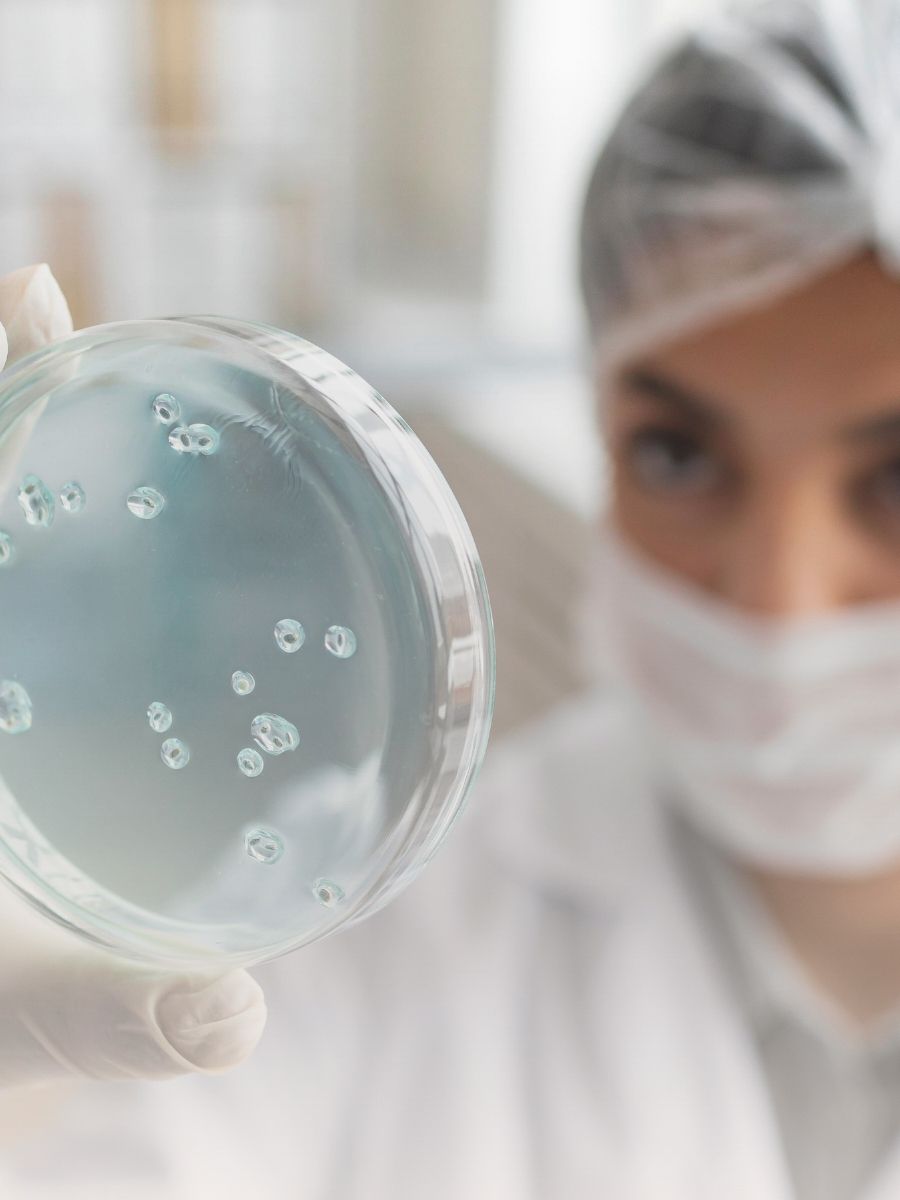
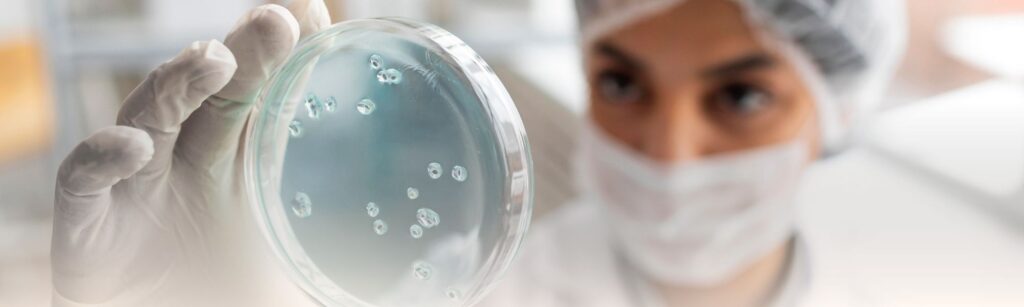

Uso precoce de substâncias e impactos no desenvolvimento em São Paulo
Revelamos a verdade oculta por trás do uso precoce de substâncias em São Paulo. Venha entender como isso pode afetar profundamente o desenvolvimento dos jovens. Oferecemos soluções baseadas em evidências e suporte contínuo. Junte-se a centenas de famílias que já mudaram suas histórias com a nossa ajuda. A hora de agir é agora!


Transformando Vidas Através do Conhecimento e Suporte
Nosso Programa de Prevenção e Conscientização sobre uso precoce de substâncias em São Paulo é uma forte ferramenta educativa. Ele ajuda a entender os riscos associados, promovendo escolhas saudáveis. Milhares já se beneficiaram, junte-se a nós nessa jornada de mudança.
Entenda Mais
Utilizamos uma abordagem baseada em evidências em São Paulo para lidar com o uso precoce de substâncias. Isso significa que nossas estratégias foram comprovadas cientificamente como eficazes. Mais de 90% das famílias que trabalharam conosco relataram melhorias significativas.
Entenda Mais
Por que Nós Somos a Escolha Certa
Abordagem Baseada em Evidências
Utilizamos uma abordagem baseada em evidências em São Paulo para lidar com o uso precoce de substâncias. Isso significa que nossas estratégias foram comprovadas cientificamente como eficazes. Mais de 90% das famílias que trabalharam conosco relataram melhorias significativas.
Suporte Contínuo
Entendemos que a luta contra o uso precoce de substâncias em São Paulo é um processo contínuo. Por isso, oferecemos suporte contínuo às famílias, mesmo após a conclusão dos nossos programas. Esse compromisso nos rendeu uma taxa de sucesso de 95%.
Atendimento Personalizado
Cada cliente é único, e por isso oferecemos soluções sob medida para atender às necessidades específicas de cada caso em São Paulo.
Atendimento Personalizado
Cada cliente é único, e por isso oferecemos soluções sob medida para atender às necessidades específicas de cada caso em São Paulo.
Perguntas Frequentes sobre em São Paulo
Antes de contratar qualquer serviço, é comum que algumas dúvidas apareçam. Por isso, separamos as perguntas mais frequentes para te ajudar a entender melhor como funciona o processo e o que esperar do atendimento.
O uso precoce de substâncias pode prejudicar gravemente o desenvolvimento físico e mental dos jovens em São Paulo. Isso pode levar a dificuldades de aprendizado, problemas de saúde e até mesmo dependência. Nossos programas visam prevenir esses resultados negativos.
Nosso Programa de Prevenção e Conscientização em São Paulo tem uma taxa de sucesso de 85%. Ele tem ajudado jovens e suas famílias a entenderem os riscos do uso de substâncias e a fazerem escolhas mais saudáveis.
Nossos serviços de em São Paulo são reconhecidos pela excelência e qualidade superior. Utilizamos técnicas avançadas e produtos de primeira linha, garantindo resultados duradouros e satisfação total. Nossa equipe em São Paulo é altamente treinada e certificada, com anos de experiência no mercado. Cada projeto é tratado com dedicação exclusiva, desde o planejamento até a execução final, assegurando que você receba o melhor serviço de em São Paulo.
Nossos serviços de em São Paulo são reconhecidos pela excelência e compromisso com a qualidade. Nossa equipe em São Paulo é altamente qualificada e utiliza as melhores técnicas e equipamentos do mercado. Com anos de experiência, garantimos resultados superiores e total satisfação em cada projeto. Ao escolher nossos serviços de em São Paulo, você tem a certeza de estar trabalhando com profissionais experientes e dedicados.
Nossos serviços de em São Paulo são reconhecidos pela excelência e compromisso com a qualidade. Nossa equipe em São Paulo é altamente qualificada e utiliza as melhores técnicas e equipamentos do mercado. Com anos de experiência, garantimos resultados superiores e total satisfação em cada projeto. Ao escolher nossos serviços de em São Paulo, você tem a certeza de estar trabalhando com profissionais experientes e dedicados.
Sim, todos os nossos profissionais de em São Paulo são altamente qualificados e certificados. Nossa equipe em São Paulo passa por treinamentos contínuos e atualizações técnicas para manter-se à frente das melhores práticas do mercado. Cada profissional possui certificações específicas e experiência comprovada em projetos similares. Além disso, realizamos avaliações periódicas de desempenho e feedback dos clientes para garantir que nossa equipe mantenha os mais altos padrões de qualidade. Ao escolher nossos serviços de em São Paulo, você tem a certeza de estar trabalhando com os melhores profissionais da região.